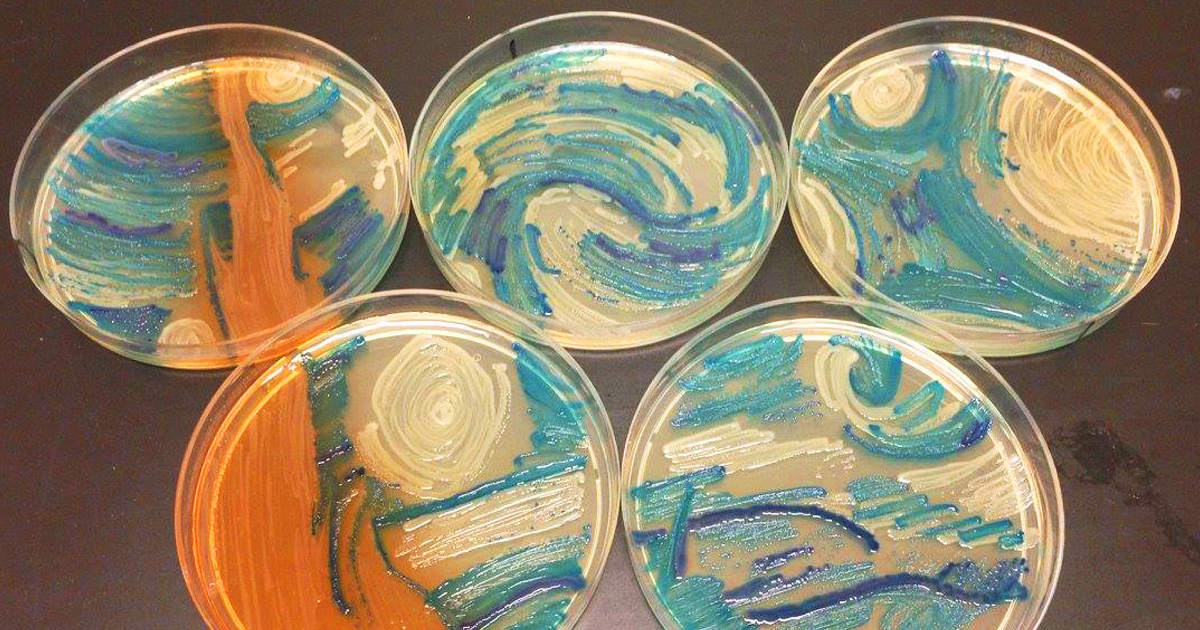

Удивительные фото Annatherapsidus Petri в природе

:format(png)/cdn.vox-cdn.com/uploads/chorus_image/image/49217367/Screen_Shot_2016-04-01_at_5.49.38_PM.0.0.png)




































































































Раздел: Другие животные